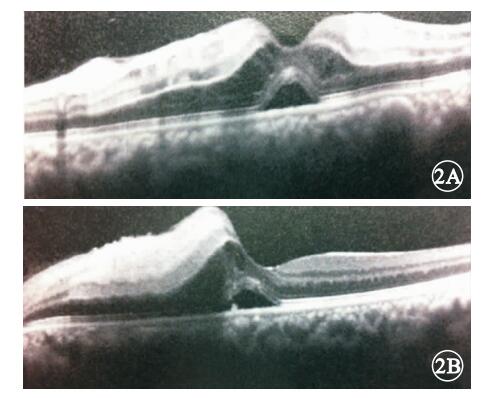

引用本文: 段文華, 李娟娟, 黎鏵. 急性胰腺炎所致遠達樣視網膜病變的臨床觀察. 中華眼底病雜志, 2014, 30(6): 618-620. doi: 10.3760/cma.j.issn.1005-1015.2014.06.020 復制
急性胰腺炎所致遠達樣視網膜病變極為少見。目前尚無大樣本臨床觀察及對照研究,主要為單一、少量的病例報道和極少數的動物實驗。我們回顧分析了近年我科診治的5例急性胰腺炎所致遠達樣視網膜病變患者的臨床資料。現將結果報道如下。
1 對象和方法
2010年2月至2013年12月云南省第二人民醫院眼科檢查確診的急性胰腺炎合并視網膜病變患者5例10只眼納入研究。納入標準:急性胰腺炎發作后視力突然下降,排除其他眼部及全身疾患,眼底表現為較為特征的以后極部為中心的片狀棉絨斑,水腫明顯[1]。患者均為男性,年齡25~41歲,平均年齡(33.00±6.44)歲。均有飲酒史,時間2~12年,其中平均飲酒量超過100 ml/d者2例。所有患者均根據相關癥狀和體征,經腹部CT、血尿淀粉酶等相關輔助檢查確診為急性胰腺炎。其中,出血壞死型2例,水腫型3例。眼部并發癥發生時間:急性胰腺炎發作后1~3 d者2例,占40%;4~6 d者2例,占40%;7 d后者1例,占20%;均為雙眼發病。
所有患者行視力、裂隙燈顯微鏡、眼壓、間接檢眼鏡、光相干斷層掃描(OCT)、眼底自身熒光(AF)、熒光素眼底血管造影(FFA)檢查。采用海德堡共焦激光眼底掃描系統行OCT、AF、FFA檢查。回顧分析患者眼部體征及影像學特征。
2 結果
患眼視力數指~0.1,均不能矯正;角膜透明,前房深度正常。瞳孔直接、間接對光反射不同程度減弱,均伴有相對性瞳孔傳入阻滯;晶狀體透明,玻璃體腔未見明顯積血及滲出。眼壓12~20 mmHg(1 mmHg=0.133 kPa),平均眼壓(15.80±2.24) mmHg。眼底可見沿視盤顳側和黃斑區血管弓環形分布的斑片狀不規則形棉絨斑,面積不等,多累及黃斑區,周邊視網膜未見異常;未見明顯出血及滲出灶;視盤顏色正常,邊界清晰;視網膜大血管走形、管徑均未見異常(圖 1)。

OCT檢查發現,所有患眼黃斑區視網膜可見神經上皮層脫離,并且水腫明顯、厚度增加,層間可見強反射信號、正常層次結構消失,中心凹不同程度抬高(圖 2)。

眼底AF檢查發現,視網膜后極部水腫區域,因水腫吸收激發光導致出現與水腫區域一致的弱熒光;水腫嚴重區域AF相對更弱,病變累及黃斑區;視盤、周邊視網膜、視網膜大血管AF均未見異常(圖 3)。

FFA檢查發現,動脈期后極部視網膜大動脈充盈,小動脈顯影不明顯,隱約可見后極部病變區域的弱熒光,但與正常區域對比尚不顯著(圖 4A);動靜脈期小動脈完全顯影,靜脈層流出現,后極部水腫區域弱熒光,與正常區域對比明顯(圖 4B);靜脈期后極部視網膜小血管出現熒光素滲漏,弱熒光區面積不變(圖 4C);晚期背景熒光減弱,熒光素滲漏區域擴大(圖 4D)。

所有患者均針對原發病進行治療,同時給予糖皮質激素、活血抗凝、改善微循環、營養神經等對癥治療。5例患者中,住院期間死亡2例。6個月后視力從發病時雙眼0.1提升至0.3者1例,眼底視網膜無灌注區范圍與發病時比較有所縮小,神經上皮層水腫明顯減輕,基本無脫離間隙;隨訪2年后視力恢復至雙眼0.5,眼底視網膜無灌注區范圍較發病時明顯縮小,神經上皮層無水腫及脫離。視力無改善者1例,雙眼視力均為0.05,眼底視網膜無灌注區范圍變化不明顯,神經上皮層水腫明顯減輕,脫離間隙減小。失訪1例。
3 討論
Inkeles和Walsh[2]在1975年首先報道了急性胰腺炎合并視網膜病變的病例,隨后的一些病例報道再次證實了酒精性胰腺炎和嚴重的視力喪失之間有很大的臨床病理關聯。目前認為該病的眼底表現和發病機制與Purtscher′s retinopathy(遠達性視網膜病變)極為類似,均為身體遠處某一部位或者器官的原發性損傷而并發眼部的癥狀,使得絕大部分患者以不同程度的視力障礙而就診,稱為遠達樣視網膜病變或遠達樣視網膜病變。此外,小血栓導致的遠達樣視網膜病變,除了急性胰腺炎外,其他多種原因也可導致類似眼底表現例如脂肪栓塞綜合征、系統性紅斑狼瘡、腎功能衰竭、先兆子癇、結締組織疾病與血管炎等的患者當中也看到有類似的眼部癥狀與體征的發生[3, 4]。
急性胰腺炎所致遠達樣視網膜病變的病理生理目前尚未明確。學者們認為可能的機制包括:動靜脈阻塞(血小板、纖維蛋白凝塊、空氣等)、淋巴淤滯、脂肪栓塞、血管微循環的紊亂。隨后這些微粒順著血液循環到達視網膜小動脈和脈絡膜血管造成阻塞,連同光感受器也受到損傷[5];微循環障礙、微栓塞阻塞視網膜小動脈,導致視網膜小動脈缺血、靜脈出血以及視神經水腫似乎是重要的發病因素[6, 7]。也有學者認為乙醇能夠加強激發各種補體,使白細胞聚集,栓塞視網膜小動脈而發病[8]。本組病患者多有酒精成癮史,與文獻報道病例相符。根據病史和相關全身及眼部的癥狀體征,本組患者診斷為遠性樣視網膜病變成立,是由非外傷性眼外病變引起的以視網膜小動脈梗塞為主要特征的病變。
Kincaid等[9]通過對一例急性胰腺炎并發視網膜病變患者的尸體行雙眼解剖發現,內層視網膜水腫廣泛且與正常視網膜組織界限清楚,內層視網膜的水腫造成了外層視網膜的病理變化。脂質栓子或者粒細胞形成的栓子可能是引發本病的原因。另外一位國外學者在對死于重癥胰腺炎的患者行解剖病理觀察后發現,大量脂肪栓塞了重要器官,包括腦,肺,心臟和腎臟[10]。也有學者提出造成眼底視盤和黃斑區損害的主要原因和不同表現不是來自于不同的栓子成分,而是因為這兩個區域的血管走行及血液供應是一個終端的表現,所以容易造成阻塞而引發相應的眼部臨床表現。
急性胰炎所致的遠達樣視網膜病變的病例極其少見。大約2%的急性胰腺炎患者會出現不同程度的視力喪失[11]。眼部變化通常出現在急性胰腺炎發病的第一周,表現為視力全部或者部分急性丟失;慢性胰腺炎并發視網膜病變的報道則非常罕見。眼底特征性表現為視網膜棉絨斑,被視盤和黃斑所局限的位于視網膜不同層次間的點狀或者火焰狀出血[12]。本組病例中,可見典型的視盤顳側和黃斑區血管弓環形分布的多發性小動脈栓塞所形成的片狀不規則形棉絨斑。遠達樣視網膜病變的病灶多位于內核層,不遮蔽血管,因此可見位于視網膜血管下的病灶,棉絨斑是白色火焰形的病灶位于視網膜神經纖維層,阻塞了視網膜的小靜脈所致[13]。OCT檢查可見黃斑區視網膜色素上皮層在中心凹處全層小范圍脫離,導致患眼出現急劇視力下降和患者主觀色覺的減弱。FFA檢查顯示視網膜深層的多發小動脈栓塞和視網膜水腫造成的背景熒光遮蔽下的小靜脈廣泛星點狀滲漏,這是由于小動脈阻塞和小靜脈壓力升高所致的特征性表現。
本病尚無特殊有效治療,關鍵在于治療原發病和對患者的良好管理,觀察全身各部位有無并發癥和病變很重要。在積極治療原發病、挽救生命的基礎上給予活血抗凝、改善微循環、營養神經、非甾體抗炎藥、控制血脂等對癥支持治療或許對患眼視力的提高和癥狀的改善會有所幫助[14, 15]。
急性胰腺炎患者視力和眼底視網膜改變情況能在一定程度上能體現急性胰腺炎的嚴重程度。因此,有必要對每一例急性胰腺炎患者行常規眼部檢查,早期識別和治療或許能避免不可逆的視網膜損傷。
急性胰腺炎所致遠達樣視網膜病變極為少見。目前尚無大樣本臨床觀察及對照研究,主要為單一、少量的病例報道和極少數的動物實驗。我們回顧分析了近年我科診治的5例急性胰腺炎所致遠達樣視網膜病變患者的臨床資料。現將結果報道如下。
1 對象和方法
2010年2月至2013年12月云南省第二人民醫院眼科檢查確診的急性胰腺炎合并視網膜病變患者5例10只眼納入研究。納入標準:急性胰腺炎發作后視力突然下降,排除其他眼部及全身疾患,眼底表現為較為特征的以后極部為中心的片狀棉絨斑,水腫明顯[1]。患者均為男性,年齡25~41歲,平均年齡(33.00±6.44)歲。均有飲酒史,時間2~12年,其中平均飲酒量超過100 ml/d者2例。所有患者均根據相關癥狀和體征,經腹部CT、血尿淀粉酶等相關輔助檢查確診為急性胰腺炎。其中,出血壞死型2例,水腫型3例。眼部并發癥發生時間:急性胰腺炎發作后1~3 d者2例,占40%;4~6 d者2例,占40%;7 d后者1例,占20%;均為雙眼發病。
所有患者行視力、裂隙燈顯微鏡、眼壓、間接檢眼鏡、光相干斷層掃描(OCT)、眼底自身熒光(AF)、熒光素眼底血管造影(FFA)檢查。采用海德堡共焦激光眼底掃描系統行OCT、AF、FFA檢查。回顧分析患者眼部體征及影像學特征。
2 結果
患眼視力數指~0.1,均不能矯正;角膜透明,前房深度正常。瞳孔直接、間接對光反射不同程度減弱,均伴有相對性瞳孔傳入阻滯;晶狀體透明,玻璃體腔未見明顯積血及滲出。眼壓12~20 mmHg(1 mmHg=0.133 kPa),平均眼壓(15.80±2.24) mmHg。眼底可見沿視盤顳側和黃斑區血管弓環形分布的斑片狀不規則形棉絨斑,面積不等,多累及黃斑區,周邊視網膜未見異常;未見明顯出血及滲出灶;視盤顏色正常,邊界清晰;視網膜大血管走形、管徑均未見異常(圖 1)。

OCT檢查發現,所有患眼黃斑區視網膜可見神經上皮層脫離,并且水腫明顯、厚度增加,層間可見強反射信號、正常層次結構消失,中心凹不同程度抬高(圖 2)。
眼底AF檢查發現,視網膜后極部水腫區域,因水腫吸收激發光導致出現與水腫區域一致的弱熒光;水腫嚴重區域AF相對更弱,病變累及黃斑區;視盤、周邊視網膜、視網膜大血管AF均未見異常(圖 3)。

FFA檢查發現,動脈期后極部視網膜大動脈充盈,小動脈顯影不明顯,隱約可見后極部病變區域的弱熒光,但與正常區域對比尚不顯著(圖 4A);動靜脈期小動脈完全顯影,靜脈層流出現,后極部水腫區域弱熒光,與正常區域對比明顯(圖 4B);靜脈期后極部視網膜小血管出現熒光素滲漏,弱熒光區面積不變(圖 4C);晚期背景熒光減弱,熒光素滲漏區域擴大(圖 4D)。

所有患者均針對原發病進行治療,同時給予糖皮質激素、活血抗凝、改善微循環、營養神經等對癥治療。5例患者中,住院期間死亡2例。6個月后視力從發病時雙眼0.1提升至0.3者1例,眼底視網膜無灌注區范圍與發病時比較有所縮小,神經上皮層水腫明顯減輕,基本無脫離間隙;隨訪2年后視力恢復至雙眼0.5,眼底視網膜無灌注區范圍較發病時明顯縮小,神經上皮層無水腫及脫離。視力無改善者1例,雙眼視力均為0.05,眼底視網膜無灌注區范圍變化不明顯,神經上皮層水腫明顯減輕,脫離間隙減小。失訪1例。
3 討論
Inkeles和Walsh[2]在1975年首先報道了急性胰腺炎合并視網膜病變的病例,隨后的一些病例報道再次證實了酒精性胰腺炎和嚴重的視力喪失之間有很大的臨床病理關聯。目前認為該病的眼底表現和發病機制與Purtscher′s retinopathy(遠達性視網膜病變)極為類似,均為身體遠處某一部位或者器官的原發性損傷而并發眼部的癥狀,使得絕大部分患者以不同程度的視力障礙而就診,稱為遠達樣視網膜病變或遠達樣視網膜病變。此外,小血栓導致的遠達樣視網膜病變,除了急性胰腺炎外,其他多種原因也可導致類似眼底表現例如脂肪栓塞綜合征、系統性紅斑狼瘡、腎功能衰竭、先兆子癇、結締組織疾病與血管炎等的患者當中也看到有類似的眼部癥狀與體征的發生[3, 4]。
急性胰腺炎所致遠達樣視網膜病變的病理生理目前尚未明確。學者們認為可能的機制包括:動靜脈阻塞(血小板、纖維蛋白凝塊、空氣等)、淋巴淤滯、脂肪栓塞、血管微循環的紊亂。隨后這些微粒順著血液循環到達視網膜小動脈和脈絡膜血管造成阻塞,連同光感受器也受到損傷[5];微循環障礙、微栓塞阻塞視網膜小動脈,導致視網膜小動脈缺血、靜脈出血以及視神經水腫似乎是重要的發病因素[6, 7]。也有學者認為乙醇能夠加強激發各種補體,使白細胞聚集,栓塞視網膜小動脈而發病[8]。本組病患者多有酒精成癮史,與文獻報道病例相符。根據病史和相關全身及眼部的癥狀體征,本組患者診斷為遠性樣視網膜病變成立,是由非外傷性眼外病變引起的以視網膜小動脈梗塞為主要特征的病變。
Kincaid等[9]通過對一例急性胰腺炎并發視網膜病變患者的尸體行雙眼解剖發現,內層視網膜水腫廣泛且與正常視網膜組織界限清楚,內層視網膜的水腫造成了外層視網膜的病理變化。脂質栓子或者粒細胞形成的栓子可能是引發本病的原因。另外一位國外學者在對死于重癥胰腺炎的患者行解剖病理觀察后發現,大量脂肪栓塞了重要器官,包括腦,肺,心臟和腎臟[10]。也有學者提出造成眼底視盤和黃斑區損害的主要原因和不同表現不是來自于不同的栓子成分,而是因為這兩個區域的血管走行及血液供應是一個終端的表現,所以容易造成阻塞而引發相應的眼部臨床表現。
急性胰炎所致的遠達樣視網膜病變的病例極其少見。大約2%的急性胰腺炎患者會出現不同程度的視力喪失[11]。眼部變化通常出現在急性胰腺炎發病的第一周,表現為視力全部或者部分急性丟失;慢性胰腺炎并發視網膜病變的報道則非常罕見。眼底特征性表現為視網膜棉絨斑,被視盤和黃斑所局限的位于視網膜不同層次間的點狀或者火焰狀出血[12]。本組病例中,可見典型的視盤顳側和黃斑區血管弓環形分布的多發性小動脈栓塞所形成的片狀不規則形棉絨斑。遠達樣視網膜病變的病灶多位于內核層,不遮蔽血管,因此可見位于視網膜血管下的病灶,棉絨斑是白色火焰形的病灶位于視網膜神經纖維層,阻塞了視網膜的小靜脈所致[13]。OCT檢查可見黃斑區視網膜色素上皮層在中心凹處全層小范圍脫離,導致患眼出現急劇視力下降和患者主觀色覺的減弱。FFA檢查顯示視網膜深層的多發小動脈栓塞和視網膜水腫造成的背景熒光遮蔽下的小靜脈廣泛星點狀滲漏,這是由于小動脈阻塞和小靜脈壓力升高所致的特征性表現。
本病尚無特殊有效治療,關鍵在于治療原發病和對患者的良好管理,觀察全身各部位有無并發癥和病變很重要。在積極治療原發病、挽救生命的基礎上給予活血抗凝、改善微循環、營養神經、非甾體抗炎藥、控制血脂等對癥支持治療或許對患眼視力的提高和癥狀的改善會有所幫助[14, 15]。
急性胰腺炎患者視力和眼底視網膜改變情況能在一定程度上能體現急性胰腺炎的嚴重程度。因此,有必要對每一例急性胰腺炎患者行常規眼部檢查,早期識別和治療或許能避免不可逆的視網膜損傷。